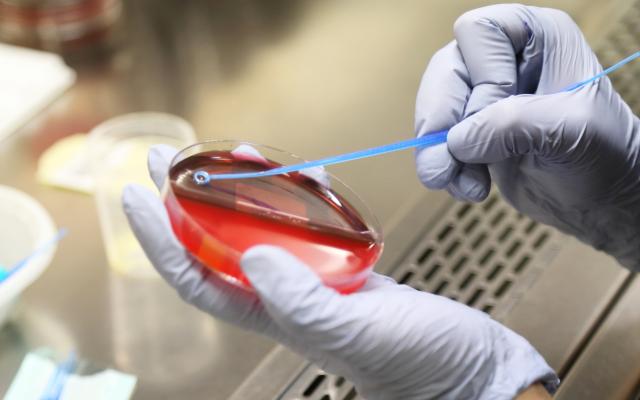
Petrischaaltje

Jop hoort van Daniëlle Kroon waar de grote variatie in het aantal bloedkweken tussen verschillende SEH’s vandaan komt. Ook bespreekt hij met Mark van den Elshout de resultaten van een onderzoek naar de invloed van preventieve hiv-medicatie op seksueel gedrag en seksueel overdraagbare aandoeningen. De warme douche is voor Bianca van der Neut van Kamers met Aandacht.
Wil je op de hoogte blijven? Schrijf je dan in voor het dossier Podcast en ontvang direct een e-mail wanneer een nieuwe aflevering online staat.